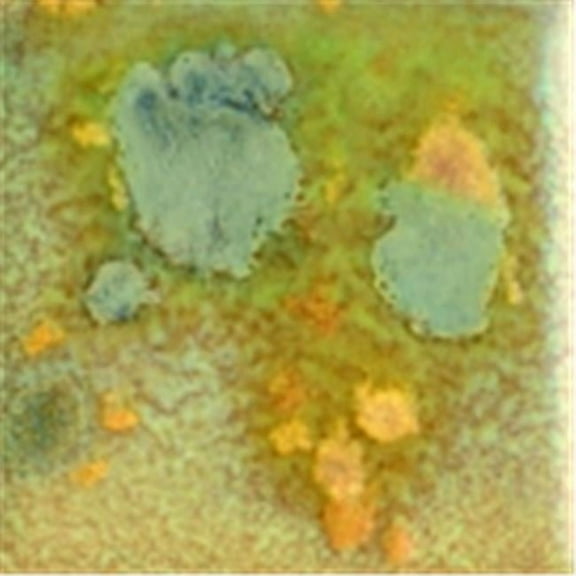
Elements Chunkies Non-Toxic Ceramic Glaze, 1 Pint, Gold Mine

Adult Coloring BooksEaster CraftsHalloween CraftsHalloween DIY CostumesMainstays Arts Crafts & SewingMichael's Arts & CraftsSt. Patrick's Day CraftsSummer CraftsValentine's Day CraftsValentine's Day Crafts for KidsWaverly InspirationsAll Beading and Jewelry MakingAll StickersArt ApronsArt Markers & PensArt Painting SuppliesArt PencilsArt Portfolio & Poster StorageArt SetsArt Tools & AccessoriesArt, Drawing & Sidewalk ChalkArtezaArtificial Floral ArrangementsArtist EaselsBeading ToolsBeadsCeramic & Pottery SuppliesCraft Cutting ToolsCraft StorageCraft SuppliesCraft Surfaces & BlanksCraft VinylCraft WireCricut EasyPressCricut ExploreCricut JoyCrochet KitsDie Cut MachinesDIY Party Favor JarsDrawing SuppliesElmer's Art SuppliesElmer's CraftBond Glue and TapeElmer's Gallon GlueElmer's Glue SticksElmer's Repair GlueElmer's School GlueElmer's School SuppliesElmer's Slime SuppliesElmer's Specialty ProductsElmer's Washable GlueEmbossingEpoxy ResinFills, Foam and Pillow FormsGemstonesGuest Books & KeepsakesHoliday & Special Occasion FabricHolographic StickersHot Glue GunsJewelry Casting SuppliesJewelry FindingsJewelry Making ToolsKnitting and Crochet KitsKnitting NeedlesKnitting Tools and SuppliesKrazy GlueLetter StickersNeedlepoint & EmbroideryNotions & Sewing AccessoriesPaper CraftingPhoto Albums & RefillsPlanner StickersPrintmakingQuillingResin JewelryResin KitsResin MoldsRibbons & FabricRibbons, Trim & EmbellishmentsScrapbooking EmbellishmentsSewing & Cutting ToolsSewing KitsSewing Machine PartsSewing Tables & Sewing StorageShop all Art Canvas Boards & Painting SurfacesShop All Arts & Craft KitsShop All Die CuttingShop All FabricShop All Fabric & Apparel CraftingShop Art SuppliesShop Fabric by BrandShop Fabric By ColorShop Fabric by MaterialShop Fabric by PatternShop Fabric by SizeShop Fabric by UsageSketchbooks & Art PaperSpeciality Crafts & HobbiesStampingStencils & TemplatesSticker PaperStickersSublimation PrintersUV ResinVinyl StickersVision BoardWaterproof StickersWedding Food Display
Adult Coloring BooksEaster CraftsHalloween CraftsHalloween DIY CostumesMainstays Arts Crafts & SewingMichael's Arts & CraftsSt. Patrick's Day CraftsSummer CraftsValentine's Day CraftsValentine's Day Crafts for KidsWaverly InspirationsAll Beading and Jewelry MakingAll StickersArt ApronsArt Markers & PensArt Painting SuppliesArt PencilsArt Portfolio & Poster StorageArt SetsArt Tools & AccessoriesArt, Drawing & Sidewalk ChalkArtezaArtificial Floral ArrangementsArtist EaselsBeading ToolsBeadsCeramic & Pottery SuppliesCraft Cutting ToolsCraft StorageCraft SuppliesCraft Surfaces & BlanksCraft VinylCraft WireCricut EasyPressCricut ExploreCricut JoyCrochet KitsDie Cut MachinesDIY Party Favor JarsDrawing SuppliesElmer's Art SuppliesElmer's CraftBond Glue and TapeElmer's Gallon GlueElmer's Glue SticksElmer's Repair GlueElmer's School GlueElmer's School SuppliesElmer's Slime SuppliesElmer's Specialty ProductsElmer's Washable GlueEmbossingEpoxy ResinFills, Foam and Pillow FormsGemstonesGuest Books & KeepsakesHoliday & Special Occasion FabricHolographic StickersHot Glue GunsJewelry Casting SuppliesJewelry FindingsJewelry Making ToolsKnitting and Crochet KitsKnitting NeedlesKnitting Tools and SuppliesKrazy GlueLetter StickersNeedlepoint & EmbroideryNotions & Sewing AccessoriesPaper CraftingPhoto Albums & RefillsPlanner StickersPrintmakingQuillingResin JewelryResin KitsResin MoldsRibbons & FabricRibbons, Trim & EmbellishmentsScrapbooking EmbellishmentsSewing & Cutting ToolsSewing KitsSewing Machine PartsSewing Tables & Sewing StorageShop all Art Canvas Boards & Painting SurfacesShop All Arts & Craft KitsShop All Die CuttingShop All FabricShop All Fabric & Apparel CraftingShop Art SuppliesShop Fabric by BrandShop Fabric By ColorShop Fabric by MaterialShop Fabric by PatternShop Fabric by SizeShop Fabric by UsageSketchbooks & Art PaperSpeciality Crafts & HobbiesStampingStencils & TemplatesSticker PaperStickersSublimation PrintersUV ResinVinyl StickersVision BoardWaterproof StickersWedding Food Display